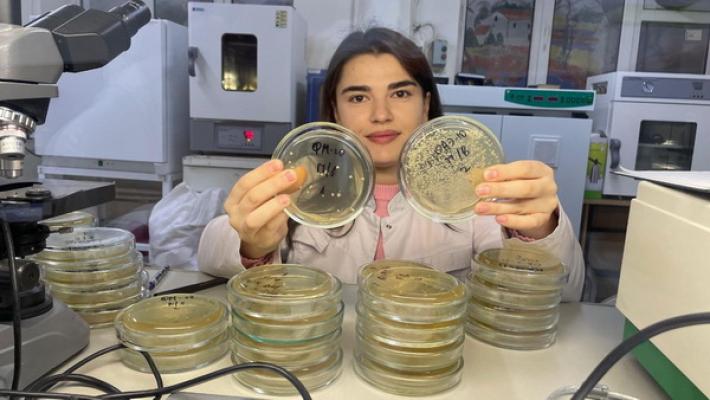

В родном доме и микроорганизмы помогают![]() Учёные центра декарбонизации АПК и региональной экономики КБГУ работают над важным инновационным проектом, в рамках которого намерены получить удобрение нового поколения на основе микроорганизмов, обитающих исключительно в чернозёмах нашей республики.
Центр декарбонизации АПК и региональной экономики КБГУ образован в 2022 году, когда вуз вошёл в программу стратегического академического лидерства «Приоритет-2030», которая призвана сконцентрировать результаты работы российских университетов для достижения национальных целей развития Российской Федерации на период до 2030 года. Цель «Приоритета» – к 2030 году сформировать в стране более 100 современных прогрессивных университетов – центров научно-технологического и социально-экономического развития.
На базе центра декарбонизации АПК и региональной экономики КБГУ идёт работа над целым рядом проектов, цель которых – повышение устойчивости агроэкосистем в условиях меняющегося климата и его влияния на сельское хозяйство и экономику в целом.
«Наша лаборатория оснащена всем необходимым оборудованием, – рассказал инженер-исследователь центра Рустам Таов. – Здесь и идёт работа над нашим проектом. Его название – «Регенеративное земледелие». Сейчас ДНК выявленных нами микроорганизмов изучается в Пермском институте экологии и генетики микроорганизмов для последующей паспортизации и введения их в ВКПМ – Всероссийскую коллекцию промышленных микроорганизмов. После завершения ДНК-анализа мы будем изучать их дальнейшие свойства не только в лаборатории, но и на практике».
![]() Актуальность проекта, по словам учёных, в мировой повестке, которую сегодня диктует глобальное изменение климата.
«Российской Федерацией подписаны основные международные документы, связанные с изменением климата, такие, например, как Парижские соглашения, – пояснил руководитель центра, кандидат сельскохозяйственных наук Амиран Занилов. – В стране даже принята соответствующая нормативно-правовая база, в том числе закон по снижению выбросов парниковых газов, Стратегия низкоуглеродного развития и сопутствующие подпрограммы. Параллельно метеорологи России обращают внимание на проблему роста температуры атмосферы, которая опережает рост на других территориях. Особенно остро реагирует на климатические изменения сельскохозяйственная отрасль. Поэтому наша задача состоит в разработке технологий, позволяющих с одной стороны получить экономически приемлемые и качественные урожаи, а с другой – использовать почвенные ресурсы для поглощения углекислого газа. Такие технологии востребованы для климатических проектов. Именно здесь свою роль и должны сыграть выделенные микроорганизмы. К сожалению, последние десятилетия интенсивной химизации АПК привели к огромным потерям плодородия почвы. Это можно назвать «дисбактериозом почвы». В ходе реализации проекта нами было выделено более 40 штаммов микроорганизмов-пробиотиков, 22 из них мы изучаем особенно активно и намереваемся «возвращать» в почву в больших концентрациях. Стоит подчеркнуть, что речь идёт о микроорганизмах, свойственных именно нашей почве, что в отличие от чужеродных микроорганизмов не нарушит структуру микрофлоры уникальных чернозёмов. В итоге мы намерены получить удобрения, которые можно вносить в почву напрямую, либо можно обогащать ими минеральные удобрения. В этом случае мы получим удобрения с ростстимулирующими и защитными свойствами от корневых гнилей. По семи штаммам лабораторные и полевые испытания уже проведены. В следующем году приступаем к испытаниям в производственных условиях».
Сейчас микроорганизмы помещают в селективные питательные среды, отслеживая скорость роста и размножения. Особо наблюдают за выделяемыми веществами – аминокислотами, гормонами и ферментами – чем их больше, тем выше КПД удобрений с их применением.
Параллельно учёные проводят аналогичное изучение микроорганизмов, обитающих в песках Аравийского полуострова. Цель – та же: изучить потенциал использования. Уже можно смело утверждать, что данный потенциал у термофильных (то есть устойчивых к высоким температурам) микроорганизмов есть: они показывают просто взрывной рост на следующий день после так называемого стресс-фактора, когда их подвергают сильной температурной нагрузке, а также высокую целлюлозоразлагающую активность. Их применение целесообразно как для борьбы с твёрдыми бытовыми отходами, так и для переработки отходов ферм и птицефабрик, в том числе в органические удобрения, – отметил Амиран Занилов. – Они аккумулируют в себе азот, который не теряется в результате выбросов в атмосферу, за счёт чего ценность удобрения в разы выше. Плюс сами микроорганизмы выделяют регуляторы роста. Такие удобрения могут послужить полной либо частично альтернативой минеральным».
На постоянной основе в центре декарбонизации АПК и региональной экономики КБГУ трудятся восемь человек: помимо руководителя Амирана Занилова, это начальник отдела Маринат Нагоева, инженеры-исследователи Рустам Таов и Динара Дударова, занятые создание биополимерных композиций. За работу климатической камеры отвечает Залим Дударов, со штаммами работает Милана Азнаева.
Центр уже отметился целым рядом заметных достижений. Так, в его стенах увидела свет научная установка для вертикально-дифференцированного учёта динамики эмиссии и поглощения углекислого газа. Благодаря работе с ней разработаны новые приёмы повышения эффективности углеродного и минерального питания в тепличных комплексах.
О других проектах центра читайте в следующих номерах «КБП».
Поделиться новостью:ЧИТАТЬ ТАКЖЕ:
| |||||||||||